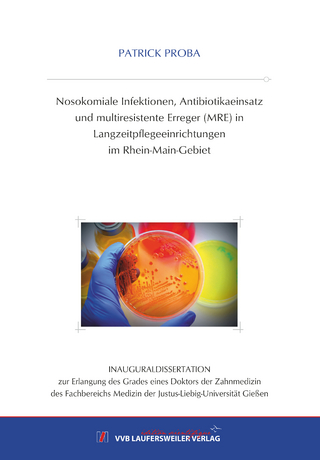
Nosokomiale Infektionen, Antibiotikaeinsatz und multiresistente Erreger (MRE) in Langzeitpflegeeinrichtungen im Rhein-Main-Gebiet

Praxisnahe Erläuterungen, Fallbeispiele und Querverweise zur neuen GOZ, GOÄ, BEMA und BEL
unbekannt
1988
|
Spitta
ISBN: 9783921883150
CHF 228,20 (inkl. MwSt)
- Titel ist leider vergriffen;
keine Neuauflage